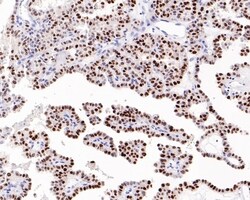
Invitrogen p21 Monoclonal Antibody (A8C11) 100 &mu;L | Buy Online | Invitrogen&trade; | Fisher Scientific

missing translation for 'onlineSavingsMsg'
Learn More
Learn More
Invitrogen™ p21 Monoclonal Antibody (A8C11)


Description
Positive control: Human cervical well-differentiated squamous cell carcinoma tissue, human thyroid carcinoma tissue, human breast carcinoma tissue. Predicted band size: 16 kDa Subcellular Location: Nucleus, Cytoplasm.
Protein p21 is a tumor suppressor protein which is an inhibitor of Cyclin-dependent kinases (CDK) and is transcriptionally activated by p53. P21 is important in the response of cells to genotoxic stress and a major transcriptional target of p53 protein. The occurrence of p21 in the nucleus executes binding and inhibition activity of cyclin dependent kinases Cdk1 and Cdk2, and blocks the transition from G1 phase into S phase or from G2 phase into mitosis after DNA damage, which enables the repair of damaged DNA. In the cytoplasm, p21 protein has an anti-apoptotic effect. P21 is able to bind to and inhibit caspase 3, as well as the apoptotic kinases ASK1 and JNK. P21 exhibits a dual function in carcinogenesis, and acts as a tumor suppressor, prevents apoptosis, and acts as an oncogene.

Specifications
Specifications
| Antigen | p21 |
| Applications | Immunohistochemistry (Paraffin) |
| Classification | Monoclonal |
| Clone | A8C11 |
| Concentration | 2 mg/mL |
| Conjugate | Unconjugated |
| Formulation | PBS with 0.1% BSA, 40% glycerol and 0.05% sodium azide; pH 7.4 |
| Gene | CDKN1A |
| Gene Accession No. | P38936 |
| Gene Alias | Activating Fragment 1; CAP20; cdk inhibitor CIP1; cdk inhibitor CIP1 (p21); CDKI; CDK-interacting protein 1; CDK-interaction protein 1; Cdkn1; CDKN1A; CDNK1A; CIP1; Cip1); cyclin dependent kinase inhibitor 1A; cyclin-dependent kinase inhibitor 1; cyclin-dependent kinase inhibitor 1A; Cyclin-dependent kinase inhibitor 1A (p21; cyclin-dependent kinase inhibitor 1A (P21); cyclin-dependent kinase inhibitor 1A (p21, Cip1); cyclin-dependent kinase inhibitor 1A variant 1; cyclin-dependent kinase inhibitor 1A variant 2; DNA synthesis inhibitor; MDA6; MDA-6; melanoma differentiation associated protein 6; melanoma differentiation-associated protein; Melanoma differentiation-associated protein 6; OTTHUMP00000016298; p21; p21>WAF1/CIP1>; p21Cip1; p21Cip1/Waf1; p21WAF; PIC1; putative cyclin-dependent kinase inhibitor 1A (p21/WAF1/CIP1); SDI1; SLC12A9; UV96; WAF1; Wild type p53 activated fragment 1 (WAF1); wild-type p53-activated fragment 1 |
| Show More |
Product Title
By clicking Submit, you acknowledge that you may be contacted by Fisher Scientific in regards to the feedback you have provided in this form. We will not share your information for any other purposes. All contact information provided shall also be maintained in accordance with our Privacy Policy.
Spot an opportunity for improvement?